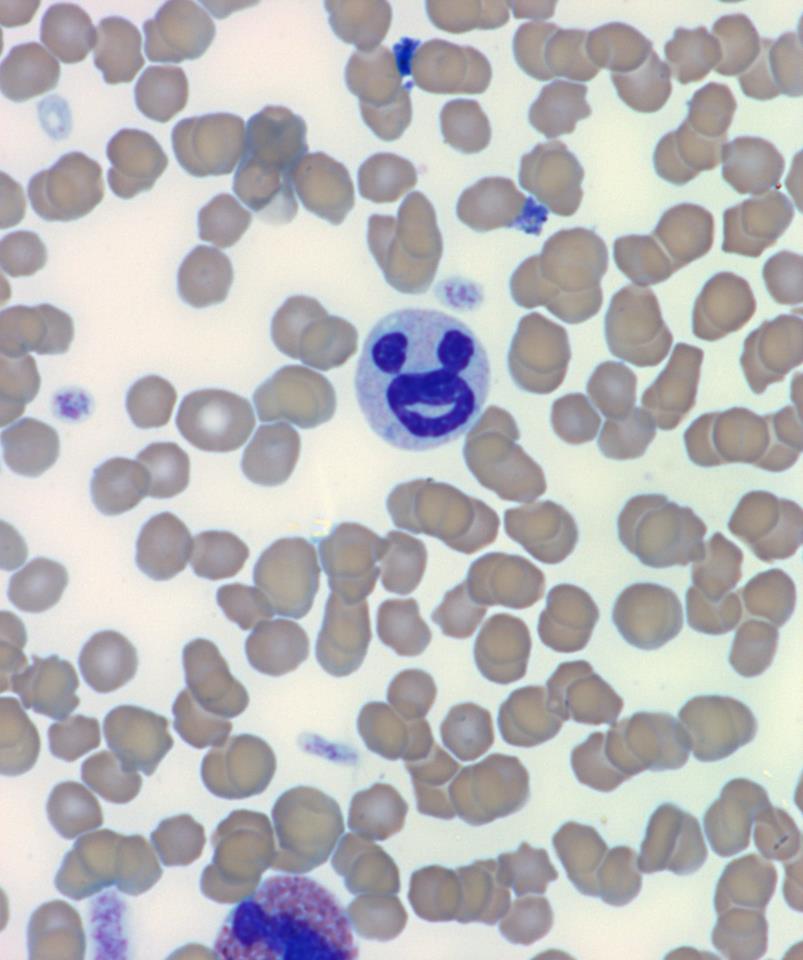
My Image 87

อันดับหนึ่ง ภาพถ่ายเกี่ยวกับneutrophil คือค่าอะไร cleverlearn-hocthongminh.edu.vn neutrophil คือค่าอะไร, absolute neutrophil count คือ, คํานวณ absolute neutrophil count, absolute neutrophil count adalah, sel neutrophil memiliki waktu hidup, how to say neutrophils, neutrophils meaning in bengali, deep neural network คือ ซึ่งมีรายละเอียดเพิ่มเติมให้ดูที่ด้านล่างค่ะ
neutrophil คือค่าอะไร Image result for neutrophils Neutrophil Stock Photos, Pictures & Royalty-Free Images – iStock Neutrophil | Medical school essentials, Medical school studying … Neutrophil Morphology | Blood Film – MedSchool High Neutrophils Low Lymphocytes : Smoking and Increased White and Red … What Is a Neutrophil Granulocyte? (with pictures) The Development Of Neutrophils. Infographics. Vector Illustration Stock … Neutrophils – 3. Une neutrophile illustration stock. Illustration du anatomique – 58448897 Joe’s Science Corner: The Role of Neutrophils in Guiding the Immune … Neutrophils Below The Normal Range In The Blood Neutropenia Vector … Neutrophil white blood cells, computer illustration. Neutrophils are … Neutrophil – Nuclear Appendages – 1. Hypersegmented neutrophil The Structure of the Neutrophil. Vector Illustration Stock Vector … Mature neutrophils with Auer rods following treatment with all-trans … Neutrophils – 2. Band neutrophil Neutrophils structure. Blood cell neutrophils. White blood cells … Neutrophil Cells | Amgen Inflammation Neutrophils Structure. Blood Cell Neutrophils. White Blood Cells … Segmented neutrophil Hypersegmented neutrophil Neutrophils picture : Biological Science Picture Directory – Pulpbits.net Neutrophil Stock Photos, Pictures & Royalty-Free Images – iStock Neutrophil extracellular traps released by neutrophils impair … Neutrophil, Variety of White Blood Cells. Consist of Multilobulated … Production of the neutrophil lineage in the bone marrow. Myeloblasts … Hypersegmented neutrophil Neutrophil Cartoons, Illustrations & Vector Stock Images – 1196 … Complete blood count (CBC) – Part 1 – Differential count (CBC With … Neutrophilia | Test Findings – MedSchool Segmented neutrophil | Medical laboratory science, Medical technology … OnlineLabels Clip Art – Neutrophil Major mechanism of action of neutrophils and macrophages in type 1 … What are Hypersegmented Neutrophils? – HealthMatters.io – Lab results … Neutrophil Vector Illustration Blood Cell Stock Vector (Royalty Free … Neutrophils | Sartorius Illustration of blood cells, showing an eosinophil, neutrophil … Toxic granulation seen in segmented neutrophil. Also noted on … Dohle Bodies In Neutrophils / Google Image Result For Http Ashimagebank … NET release. NET formation may be one of the main neutrophil functions … Neutrophils stock image. Image of polymorphonuclear, white – 23724387 Neutrophil Photos and Premium High Res Pictures – Getty Images Neutrophil مراحل بلوغ رده نوتروفیلی Maturation of Neutrophils Neutrophil 스톡 사진(지금 편집) 332267135 Melanin inclusions in the neutrophils of a patient with metastatic … Neutrophil function in cancer is dictated by environmental cues … Hypersegmented neutrophil Neutrophils Function | Biology Dictionary Role of neutrophils in host microbial interactions – periobasics.com Neutrophil morphology as observed by electron microscopy. Neutrophils … Band neutrophil Roles of neutrophils in cancer growth and progression – Galdiero – 2018 … Structure Neutrophil Vector Illustration Stock Vector 329385257 … Medical Laboratory and Biomedical Science: Howell-Jolly-like bodies in … Integration of factors determining neutrophil lifespan. The bone marrow … Neutrophil Stock Illustrations – 1,144 Neutrophil Stock Illustrations … Absolute Neutrophil Count (ANC) Neutrophils. Blood smear stock image. Image of microscopic – 93292409 Neutrophils | Blood Film – MedSchool Pin on Veterinary Anatomy & Physiology Mechanism for the release of neutrophil extracellular traps (NETs … Hypersegmented neutrophil stock photo. Image of microbiology – 58379026 Frontiers | How Neutrophils Shape Adaptive Immune Responses | Immunology Ehrlichiosis | Lyme Disease High Neutrophils Low Lymphocytes : High CD3 + lymphocytes, low CD66b … Phagocyte Neutrophil Neutrocytes Granulocytes White Blood Cell Cells … Structure of neutrophil extracellular trap. Neutrophil extracellular … 10 Interesting White Blood Cell Facts | My Interesting Facts Neutrophil death and NET formation. Aging neutrophils die by apoptosis … Neutrophil Cartoons, Illustrations & Vector Stock Images – 953 Pictures … Immunity, Illness, and Infection – Together | Role of neutrophil activation in inflammatory liver disease … Figure 1 from An overview of neutrophil disorders and their diagnosis … Hypogranular Neutrophils File:20100825 023736 Neutrophil.jpg – Wikipedia, the free encyclopedia Frontiers | A NET Outcome | Immunology Figure 5: Higher magnification of Pelger-Huet neutrophils in an … Representative images of neutrophil extracellular trap (NET)-like … Neutrophil responses to viral infection. Neutrophils have an important … Neutrophil Vector Image – 1870509 | StockUnlimited Neutrophil + monocyte | Stain: May-Grünwald-Giemsa. | Flickr Hypersegmented neutrophil stock image. Image of infection – 56807153 neutrophil Archives | eClinpath VETERINARY HEMATOLOGY DEXTERVET: happy neutrophil Basophilia Article VETERINARY HEMATOLOGY DEXTERVET: neutrophil face Neutrophils, neutrophils function, causes of low or high absolute … Mechanisms of neutrophil- and macrophage-driven resolution.A.Depletion … Immature neutrophils from a cow with severe inflammation | eClinpath